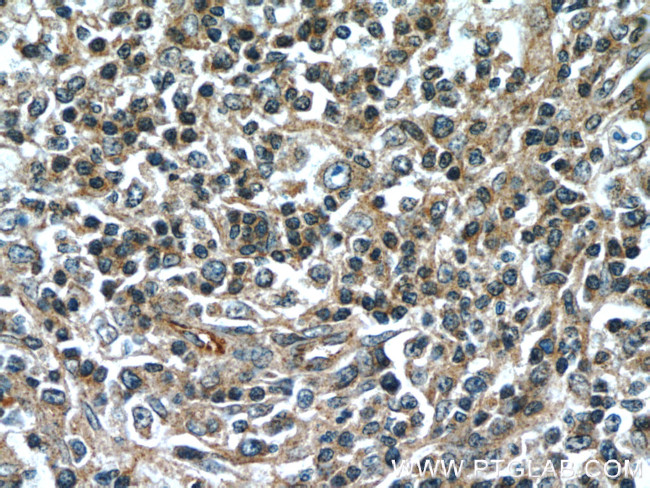
SCGF Antibody in Immunohistochemistry (Paraffin) (IHC (P))

Search
Proteintech
SCGF Monoclonal Antibody (4H11E4)
{{$productOrderCtrl.translations['antibody.pdp.commerceCard.promotion.promotions']}}
{{$productOrderCtrl.translations['antibody.pdp.commerceCard.promotion.viewpromo']}}
{{$productOrderCtrl.translations['antibody.pdp.commerceCard.promotion.promocode']}}: {{promo.promoCode}} {{promo.promoTitle}} {{promo.promoDescription}}. {{$productOrderCtrl.translations['antibody.pdp.commerceCard.promotion.learnmore']}}
产品信息
60295-1-IG
种属反应
宿主/亚型
分类
类型
克隆号
抗原
偶联物
形式
浓度
规格
纯化类型
保存液
内含物
保存条件
运输条件
产品详细信息
Immunogen sequence: GHGARGAER EWEGGWGGAQ EEEREREALM LKHLQEALGL PAGRGDENPA GTVEGKEDWE MEEDQGEEEE EEATPTPSSG PSPSPTPEDI VTYILGRLAG LDAGLHQLHV RLHALDTRVV ELTQGLRQLR NAAGDTRDAV QALQEAQGRA EREHGRLEGC LKGLRLGHKC FLLSRDFEAQ AAAQARCTAR GGSLAQPADR QQMEALTRYL RAALAPYNWP VWLGVHDRRA EGLYLFENGQ RVSFFAWHRS PRPELGAQPS ASPHPLSPDQ PNGGTLENCV AQASDDGSWW DHDCQRRLYY VCEFPF (19-323 aa encoded by BC005810)
靶标信息
This gene encodes a member of the C-type lectin superfamily. The encoded protein is a secreted sulfated glycoprotein and functions as a growth factor for primitive hematopoietic progenitor cells. An alternative splice variant has been described but its biological nature has not been determined.
仅用于科研。不用于诊断过程。未经明确授权不得转售。
生物信息学
蛋白别名: b SCGF; beta SCGF; betaSCGF; bSCGF; C-type (calcium dependent, carbohydrate-recognition domain) lectin, superfamily member 3; C-type lectin domain family 11 member A; C-type lectin superfamily member 3; hCG_22930; Lymphocyte secreted C-type lectin; lymphocyte secreted glycoprotein; lymphocyte secreted long form of C-type lectin; Osteolectin; p47; SCGF b; SCGF beta; SCGF β; SCGFb; SCGFbeta; SCGFβ; Stem cell growth factor; stem cell growth factor; lymphocyte secreted C-type lectin; unnamed protein product; β SCGF; βSCGF
基因别名: CLEC11A; CLECSF3; LSLCL; P47; SCGF
UniProt ID: (Human) Q9Y240
Entrez Gene ID: (Human) 6320